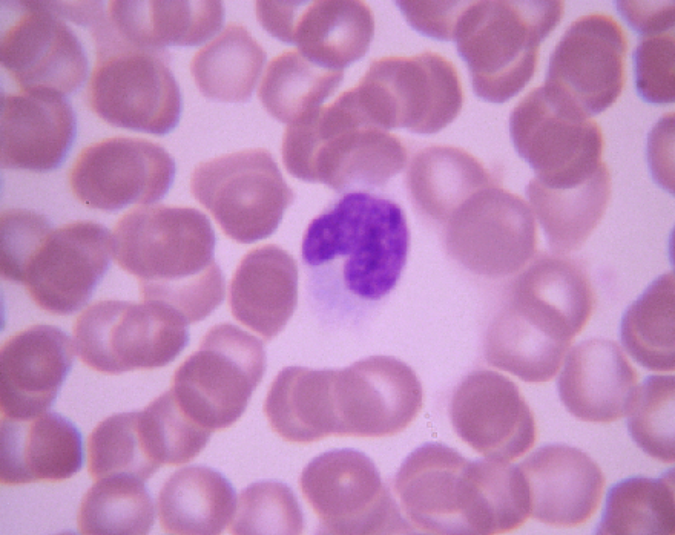

4.3.5 单核细胞
-
1 内容
-
2 测验
上一节
下一节
形态
体积最大的白细胞,直径 14-20μm;核呈肾形、马蹄铁形等,染色质细而松散,着色较浅。胞质较多,染成深浅不匀的灰蓝色。
单核细胞光镜像(Wright-Giemsa,10×40):
单核细胞透射电镜像:

功能
单核细胞在血液中停留12-48小时,然后进入结缔组织或其他组织,分化为巨噬细胞等具有吞噬功能的细胞。
单核细胞功能示意图:

单核细胞功能示意图:



